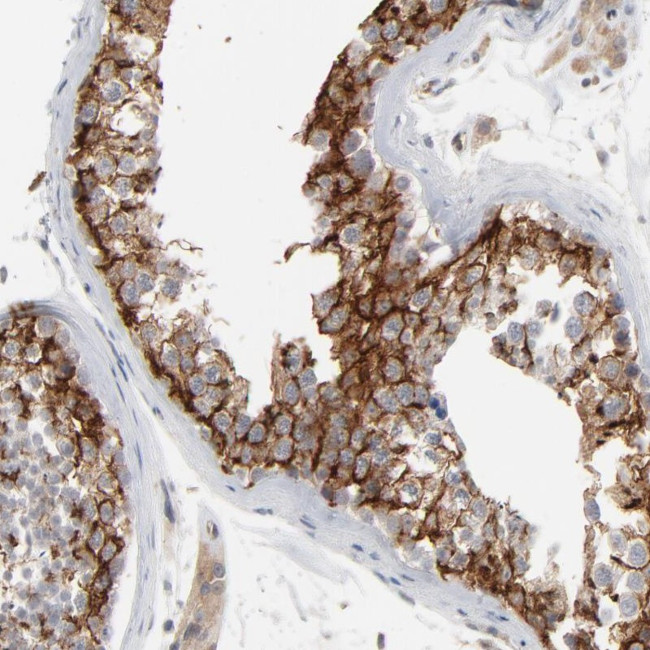
ITPR3 Antibody in Immunohistochemistry (Paraffin) (IHC (P))

Search
Invitrogen
ITPR3 Polyclonal Antibody
{{$productOrderCtrl.translations['antibody.pdp.commerceCard.promotion.promotions']}}
{{$productOrderCtrl.translations['antibody.pdp.commerceCard.promotion.viewpromo']}}
{{$productOrderCtrl.translations['antibody.pdp.commerceCard.promotion.promocode']}}: {{promo.promoCode}} {{promo.promoTitle}} {{promo.promoDescription}}. {{$productOrderCtrl.translations['antibody.pdp.commerceCard.promotion.learnmore']}}
产品信息
PA5-52021
种属反应
宿主/亚型
分类
类型
抗原
偶联物
形式
浓度
规格
纯化类型
保存液
内含物
保存条件
运输条件
RRID
产品详细信息
Immunogen sequence: ITSTKNEKIF QESIGLAIHL LDGGNTEIQK SFHNLMMSDK KSERFFKVLH DRMKRAQQET KSTVAVNMND LGSQPHEDRE PVDPTTKGRV ASFSIPGSSS RYSLGPSLRR GHEVSERVQS SEMGTSVLIM QPILRFLQLL CENHNRD
Highest antigen sequence identity to the following orthologs: Mouse - 86%, Rat - 89%.
靶标信息
This gene encodes a receptor for inositol 1,4,5-trisphosphate, a second messenger that mediates the release of intracellular calcium. The receptor contains a calcium channel at the C-terminus and the ligand-binding site at the N-terminus. Knockout studies in mice suggest that type 2 and type 3 inositol 1,4,5-trisphosphate receptors play a key role in exocrine secretion underlying energy metabolism and growth.
仅用于科研。不用于诊断过程。未经明确授权不得转售。
篇参考文献 (0)
生物信息学
蛋白别名: inositol 1,4,5-triphosphate receptor, type 3; Inositol 1,4,5-trisphosphate-gated calcium channel ITPR3; insP3R3; IP3 receptor; IP3 receptor isoform 3; IP3R-3; Type 3 inositol 1,4,5-trisphosphate receptor; Type 3 InsP3 receptor
基因别名: CMT1J; IP3R; IP3R-3; IP3R3; ITPR3
UniProt ID: (Human) Q14573
Entrez Gene ID: (Human) 3710